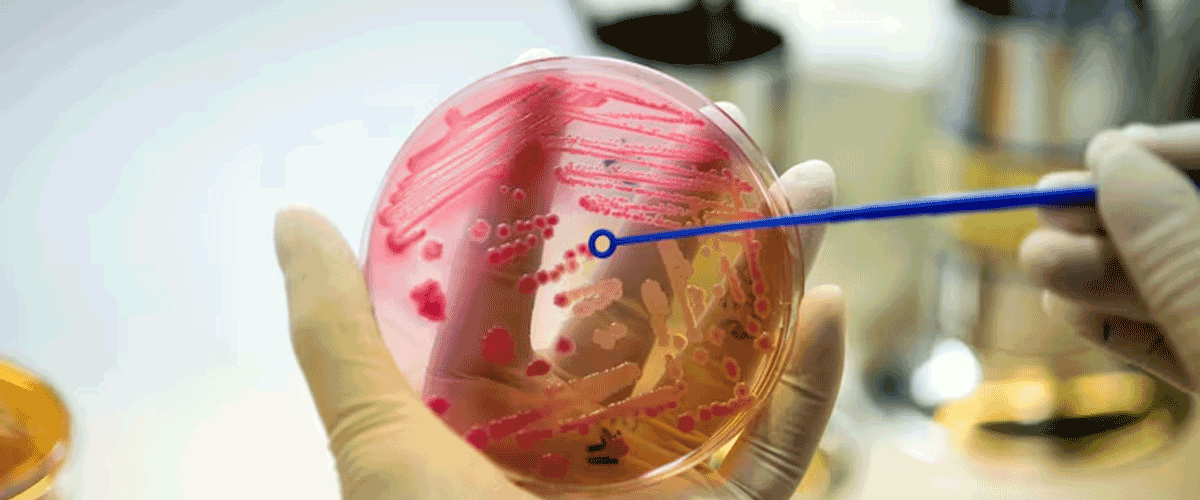
Study Links Placental Microplastics to Increased Risk of Miscarriage

(An Autonomous Body Recognized by Ministry of Commerce & Industry, Government of India)
Competency based placement focussed Education | Training | Research | Consultancy
Study Links Placental Microplastics to Increased Risk of Miscarriage
A new study published in eBioMedicine has revealed that higher levels of microplastics in the placenta are associated with a greater risk of spontaneous miscarriage during the first trimester. Researchers found microplastics in all placentas tested, with polyvinyl chloride (PVC) making up more than half of the detected particles. Older women, and those who frequently consumed bottled water or seafood, showed higher microplastic concentrations, indicating lifestyle and age-related exposure factors.
The findings suggest that microplastic accumulation poses significant health risks during pregnancy, a particularly vulnerable period for both mother and fetus. With global plastic pollution exceeding 57 million tons annually, microplastics have become pervasive—detected in food, water, air, and even human organs. Given that 10%–20% of pregnancies end in miscarriage, the study’s authors urge stronger policies to regulate plastic pollution and limit human exposure to these persistent contaminants.
03-11-2025
📰 Recent News
- Seattle Cement Plant Faces Backlash Over Tire Burning and Air Pollution
- Tesla Cleared of Permit Violations, but Wastewater Discharge Sparks Local Concerns
- Toxic ‘Forever Chemicals’ Found at Alarming Levels in UK Town Residents
- PFAS-Contaminated Water Linked to Higher Childhood Cancer Risk
- Hidden Risks in ‘BPA-Free’ Baby Products Revealed
- EPA Moves to Relax Cancer-Causing Gas Limits, Sparking Health vs. Supply Debate
- Middle East Conflict Raises Long-Term Environmental and Health Risks
- Imported Plastic Waste Fuels Pollution Crisis in Southern Türkiye
- Underwater EMF Exposure May Pose Risks to Marine Life, Review Finds
- Study Raises Concerns Over Toxic Emissions from Childrens Mattresses
